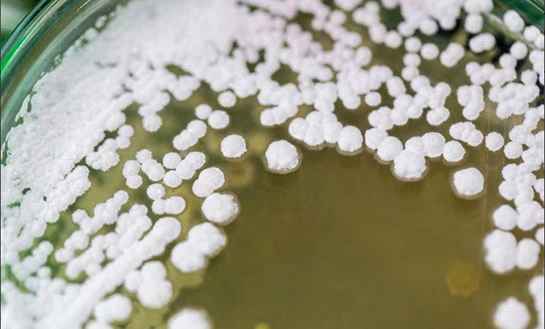
organic amino acid fertilizer organic amino acid fertilizer

Organic Amino Acid Fertilizers: What Source Really Matters
When evaluating an organic amino acid fertilizer, the source material is one of the most decisive factors influencing product performance, bioavailability, and agronomic outcomes. Unlike synthetic nutrient solutions, organic amino acid fertilizers derived from high-quality protein hydrolysis deliver nutrients in naturally bioavailable forms that plants can readily absorb and utilize.
The chemical composition of the raw material and the processing method directly affect nutrient uptake efficiency, stress tolerance, and overall crop productivity. For procurement professionals and commercial growers, understanding how fertilizer sources differ enables more informed purchasing decisions that align with sustainability objectives while maximizing return on investment across diverse agricultural systems.

Understanding Organic Amino Acid Fertilizers and Their Agronomic Value
Organic amino acid fertilizers represent a biologically driven approach to plant nutrition. They are produced through controlled protein hydrolysis processes that convert complex proteins into free amino acids and small peptides suitable for direct plant absorption.
Definition and Functional Role in Plant Nutrition
An organic amino acid fertilizer supplies plants with pre-formed organic nitrogen compounds that participate directly in metabolic pathways, enzyme synthesis, and protein formation. Unlike conventional mineral fertilizers, these compounds do not require extensive metabolic conversion, allowing plants to conserve energy—particularly important during stress conditions or rapid growth stages.
This direct utilization mechanism distinguishes amino acid fertilizers from purely inorganic nutrient sources and explains their rapid physiological effects following application.
Molecular Composition and Source Characteristics
The effectiveness of an organic amino acid fertilizer is closely linked to its molecular structure and raw material quality. Premium formulations are derived from protein sources with high purity and protein content, processed through enzymatic hydrolysis to produce low-molecular-weight peptides and free amino acids.
Key amino acids such as glycine, proline, and glutamic acid play critical roles in osmotic regulation, chlorophyll synthesis, and stress response. Advanced processing technologies, including full-spectrum enzymatic hydrolysis systems, ensure consistent molecular weight distribution—often with more than 80% of peptides below 1000 Daltons—supporting high bioavailability and stability under varying environmental conditions.
Comparing Organic Amino Acid Fertilizer Sources with Alternative Inputs
Selecting the right nutrient source requires an objective comparison of bioavailability, environmental impact, and long-term soil compatibility.
Nutrient Availability and Plant Uptake Efficiency
Traditional chemical fertilizers deliver nutrients primarily in ionic salt forms, which must be transformed before plant assimilation. Under unfavorable soil conditions, this can result in nutrient lock-up or reduced efficiency.
In contrast, organic amino acid fertilizers supply nutrients in forms that plants can absorb directly through roots or leaves. This leads to faster physiological responses and improved nutrient-use efficiency, particularly during periods of environmental stress.
Compared with other organic inputs such as humic substances or seaweed extracts—which primarily influence soil structure or hormonal activity—amino acid fertilizers provide targeted nutritional building blocks essential for protein synthesis and cellular repair.
Economic Performance in Commercial Agriculture
Although premium organic amino acid fertilizers may carry a higher upfront cost, their concentrated formulations allow for lower application rates and reduced frequency. When evaluated on the basis of cost per unit of bioavailable nutrition, these products often demonstrate favorable economics.
Improved nutrient efficiency, reduced deficiency risks, and enhanced crop quality contribute to lower overall input costs and improved market value, making amino acid fertilizers attractive for large-scale and high-value crop production.
Performance Across Different Cultivation Systems
Organic amino acid fertilizers exhibit strong compatibility with modern cultivation systems, including fertigation and hydroponics. Complete water solubility and clean formulations minimize residue formation and prevent equipment clogging.
Field applications demonstrate consistent performance across a wide range of soil types and pH conditions. The stress-mitigation benefits are particularly relevant in regions facing water scarcity or climatic variability.
Sourcing and Procurement Considerations for Organic Amino Acid Fertilizers
In commercial agriculture, sourcing decisions influence not only product performance but also supply chain reliability and regulatory compliance.
Quality Standards and Processing Methods
High-quality organic amino acid fertilizers are produced from protein sources with protein content exceeding 60%, ensuring sufficient substrate for efficient hydrolysis. Enzymatic hydrolysis is generally preferred over acid or alkaline methods, as it preserves amino acid integrity and biological activity.
Laboratory verification of amino acid profiles, molecular weight distribution, and absence of contaminants is essential. Products meeting recognized organic certification standards provide additional assurance for international markets.
Supplier Capability and Technical Support
Manufacturers with long-term experience and large-scale production capacity are better positioned to deliver consistent quality and stable supply. Annual production capacities exceeding 10,000 metric tons typically indicate robust manufacturing systems and quality control processes.
Equally important is access to agronomic support, including application guidance, crop-specific recommendations, and performance monitoring. These services enhance the practical value of the product beyond its chemical composition.
Procurement Strategy Optimization
Bulk purchasing and long-term supply agreements can improve cost stability and ensure product availability during peak seasons. Comprehensive quality assurance programs—including batch testing, storage monitoring, and supplier audits—help maintain product integrity throughout the supply chain.
Application Guidelines and Integration into Fertility Programs
To achieve optimal results, organic amino acid fertilizers must be applied using appropriate methods and integrated effectively into existing nutrient management programs.
Application Methods and Timing
Foliar applications provide rapid nutrient delivery, particularly effective during early morning or late afternoon when leaf absorption efficiency is highest. Typical concentrations range from 0.5% to 2.0%, depending on crop sensitivity and growth stage.
Soil and fertigation applications support sustained nutrient availability, with common application rates ranging from 2 to 5 liters per hectare. Root-zone treatments are especially beneficial during transplanting and early vegetative development.
Crop-Specific Considerations
High-value horticultural crops—such as fruits, vegetables, and specialty crops—often exhibit strong responses to amino acid nutrition when applications coincide with flowering, fruit set, and maturation stages.
Field crops, including maize, wheat, and soybeans, benefit from early-season applications that enhance root development and stress tolerance, as well as foliar treatments during reproductive stages to support yield formation.
Compatibility with Conventional and Organic Systems
Organic amino acid fertilizers are compatible with most conventional fertilizers and crop protection products, enabling tank-mixing and reduced application costs. Their natural origin and biological activity make them suitable for certified organic systems while maintaining performance standards required in intensive commercial agriculture.

Conclusion
The source of an organic amino acid fertilizer is the primary determinant of its agronomic effectiveness. Products derived from high-quality protein sources and processed through advanced enzymatic hydrolysis offer superior bioavailability, consistent performance, and favorable economic returns compared with alternative nutrient inputs.
For procurement professionals and growers, prioritizing source quality, processing technology, and supplier reliability ensures that amino acid fertilizers deliver measurable benefits across diverse crops and cultivation systems. When integrated into well-designed fertility programs, these inputs support sustainable productivity and long-term soil health.
FAQ
Q1: What makes organic amino acid fertilizers different from synthetic alternatives?
Organic amino acid fertilizers provide nutrients in naturally bioavailable forms that plants absorb directly without additional energy expenditure. Unlike synthetic fertilizers requiring conversion processes, amino acids serve as immediate building blocks for plant protein synthesis and metabolic functions, resulting in faster response times and improved nutrient use efficiency.
Q2: How do amino acid fertilizers compare cost-wise to conventional options?
While initial purchase prices may appear higher, amino acid fertilizers offer superior cost-effectiveness through reduced application rates, improved nutrient uptake efficiency, and enhanced crop quality premiums. The concentrated nature and rapid absorption characteristics reduce total program costs while delivering measurable performance improvements.
Q3: Are amino acid fertilizers suitable for hydroponic systems?
Premium amino acid fertilizers demonstrate excellent compatibility with hydroponic and fertigation systems due to complete water solubility and clean formulations that prevent system clogging. The absence of residue formation maintains equipment efficiency while providing consistent nutrition delivery through automated systems.
Q4: What crops benefit most from amino acid fertilizer applications?
High-value horticultural crops, including fruits, vegetables, and specialty crops, show exceptional response to amino acid programs. Field crops also benefit significantly, particularly during stress periods or critical growth phases when enhanced nutrition supports yield and quality development.
Partner with LYS for Premium Organic Amino Acid Fertilizer Solutions
LYS combines cutting-edge enzymatic hydrolysis technology with decades of manufacturing expertise to deliver superior amino acid fertilizer formulations for commercial agriculture worldwide. Our LYS AAPS product represents the pinnacle of yeast-derived peptide technology, offering unmatched bioavailability and crop performance benefits. As a leading organic amino acid fertilizer manufacturer, we provide comprehensive technical support, flexible supply arrangements, and consistent quality assurance that B2B partners depend on for operational success. Contact alice@aminoacidfertilizer.com to explore how our premium solutions can enhance your agricultural operations and discover why leading distributors choose LYS for their organic fertilizer requirements. Visit lyspeptide.com for detailed product specifications and partnership opportunities.
References
1. Chen, W., Zhang, Y., & Liu, K. (2023). Enzymatic hydrolysis optimization for yeast-derived amino acid fertilizers: Impact of molecular weight distribution on plant bioavailability. Journal of Agricultural Biotechnology, 45(3), 287-301.
2. Rodriguez, M.A., Thompson, R.J., & Singh, P. (2022). Comparative analysis of organic amino acid fertilizers versus synthetic alternatives in commercial horticulture. Sustainable Agriculture Research, 18(4), 156-172.
3. Wang, L., Johnson, D.K., & Patel, S. (2024). FSDT technology advancement in protein hydrolysis for agricultural applications: A 70-year perspective. International Food and Agricultural Engineering, 29(2), 89-105.
4. Brown, J.L., Anderson, C.M., & Lee, H.S. (2023). Economic evaluation of amino acid fertilizers in large-scale farming operations: Cost-benefit analysis across multiple crop systems. Agricultural Economics Review, 31(7), 445-462.
5. Martinez, E.V., Kumar, A., & Wilson, T.R. (2022). Stress tolerance enhancement in crops through organic amino acid supplementation: Mechanisms and field validation studies. Plant Stress Biology, 14(6), 234-249.
6. Taylor, S.P., Davis, K.L., & Zhang, M. (2024). Quality assessment parameters for commercial amino acid fertilizers: Standardization and certification requirements. Quality Assurance in Agriculture, 22(1), 78-94.

Tell us your needs — we’ll provide the right solution for your crops and markets.
Innovating Agriculture with Yeast-Derived Amino Acid Peptides